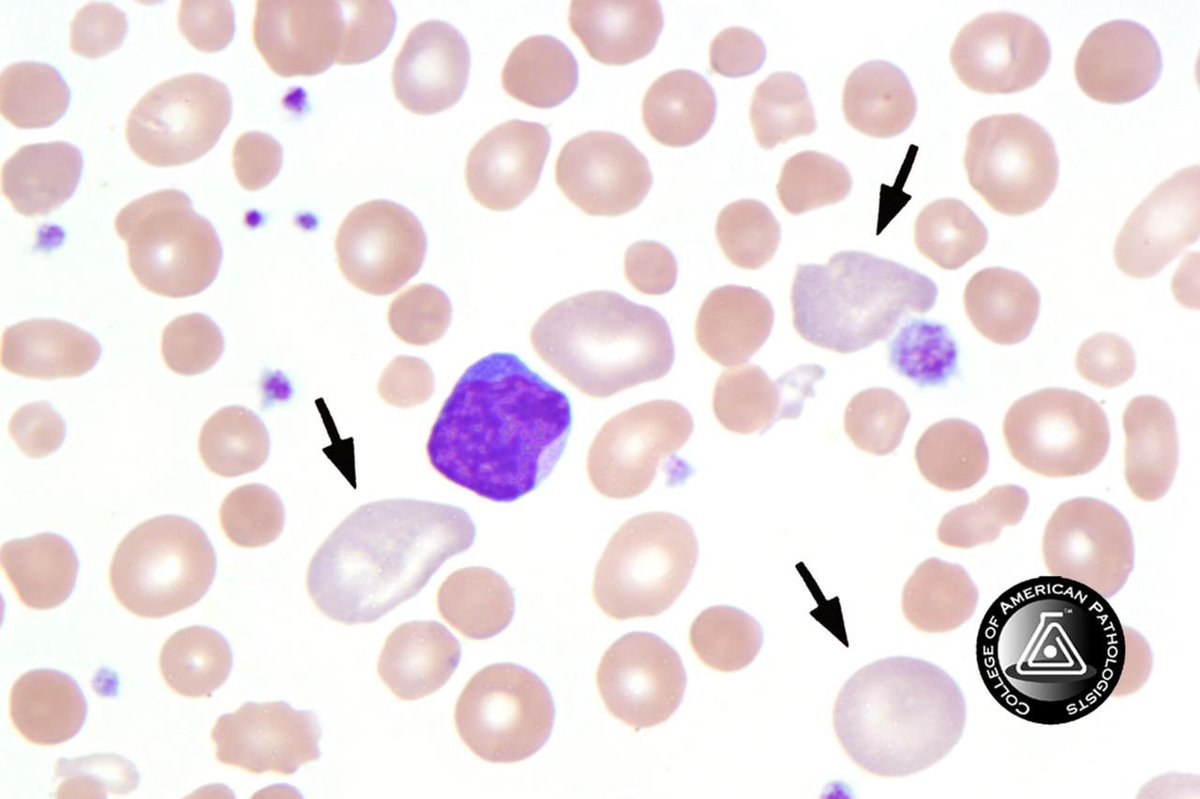

1️⃣ #ماذا_تعرف_عن_المختبر
ماذا تعرف عن مختبر الدم ؟ 🩸💉
مجموعة من الاسئلة يومياً لاختبار معلوماتك
#ثريد 👇🏼
ماذا تعرف عن مختبر الدم ؟ 🩸💉
مجموعة من الاسئلة يومياً لاختبار معلوماتك
#ثريد 👇🏼
🩸1- The only anemia that is microcytic hypochromic but not related to iron deficiency is ❔
Thalassemia ✔️
*
Polychromatic ✔️
If screening test is positive for hemoglobin S , what is the confirmatory test to be performed❔
Electrophoresis ✔️
Which of the normal and abnormal hemoglobin migrate faster in electrophoresis ❔
Hb H ✔️
All the following factors influence ESR except ❔
Blood in citrate tube ✔️
جاري تحميل الاقتراحات...